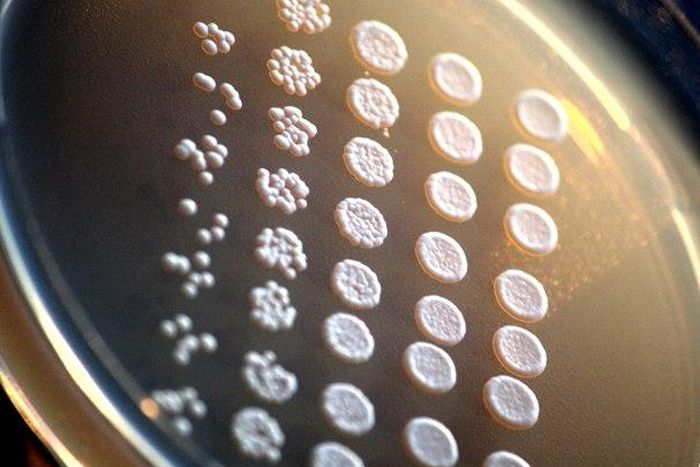
The team first studied autophagy in an engineered version of a simple  budding yeast called Saccharomyces cerevisiae, a fungus that is central to  the fermentation needed for winemaking and beer brewing.

How a simple fungus paved the way to the Nobel Prize
)
Recycling has been an essential human activity ever since early cave dwellers fashioned new tools from flint and bone reclaimed from old or broken implements.
You could even say that it is in our genes. Take, for example, autophagy, the process living cells use to deconstruct and reuse their broken or worn-out components.
Juleen Zierath, a biologist at Sweden’s Karolinska Institute and a member of the Nobel Committee for Physiology or Medicine, says that humans need to replace up to 300 grams of protein in our bodies every day. Yet we only eat on average about 70 grams of protein a day. The rest is salvaged in cells through processes like autophagy. “Proteins are recycled with this sophisticated machinery so that we can sustain and survive,” Zierath said in an interview.
Much about autophagy, which occurs in life as diverse as mammals and single-celled yeast, remained a mystery until Japanese cell biologist Yoshinori Ohsumi started exploring it in the 1990s. His biological detective work won him the Nobel Prize in Physiology or Medicine in October. In recent years, Ohsumi used for his research a ground breaking microscope made by GE Healthcare Life Sciences.
This research laid the foundation for the team’s later work, which relied on the increasingly sophisticated microscopes that became available and allowed scholarly work on autophagy to explode.
Understanding autophagy is important because cells can’t survive without it. In addition to replenishing the raw materials they need to build new proteins and structures throughout an organism’s life, the process also plays a critical role in clearing damaged proteins that can become toxic when allowed to accumulate. Autophagy is also an important part of our immune system, neutralising and dispatching invading pathogens, and it plays a role in diseases such as cancer, Parkinson’s and Alzheimer’s diseases.
Before Ohsumi started working on autophagy, “the machinery was unknown,” Zierath said. “How the system was working was unknown. And whether or not it was involved in disease was unknown. Dr. Ohsumi was interested in problems that other investigators stayed away from.”
In the late 1990s, Ohsumi needed to resolve smaller and smaller structures to advance his research, and he started bumping against the limits of the microscopes he had available. Also, pumping more light into the microscope to resolve finer details can create heat that can kills cells. “At the resolution Ohsumi’s lab was working at, the question becomes ‘Are you watching biology in action, or are you watching a microscopic egg fry?” said Paul Goodwin, the science director at GE Healthcare Life Sciences.
In 2001, in order to move forward, Ohsumi’s team began employing a state-of-the-art fluorescence microscopy system called DeltaVision, which was later bought by GE Healthcare Life Sciences. The system handles biological materials much more gently, allowing researchers to record clear, highly magnified time-lapse images of biological processes as they occur. With this, Ohsumi’s group could start seeing the specifics of how vesicles called autophagosomes form around the cell’s contents and fuse with the yeast’s vacuole. This is the part that produces enzymes capable of breaking apart larger molecules. That’s also where the proteins responsible for autophagy localise over time.
The next step for this kind of research probably involves super-resolution microscopy of yeast. In the super resolution space, GE Healthcare offers the DeltaVision OMX SR, an advanced multimode, super-resolution system that produces images in two and three dimensions. Advanced research in super resolution has the potential to unlock more of autophagy’s secrets and open new doorways to translate this basic science into disease treatment and prevention, Goodwin said.
“In biology, we often think about making things — DNA, proteins — but we don’t think about what happens on the other end. And as important as making proteins is, how they get broken down and reused is just as important to understand,” Goodwin said. “Imagine if you could harness this process to create new therapies. Imagine if you could disturb this recycling process only in cancer cells and kill only them.”
)
)
)
)
)
)